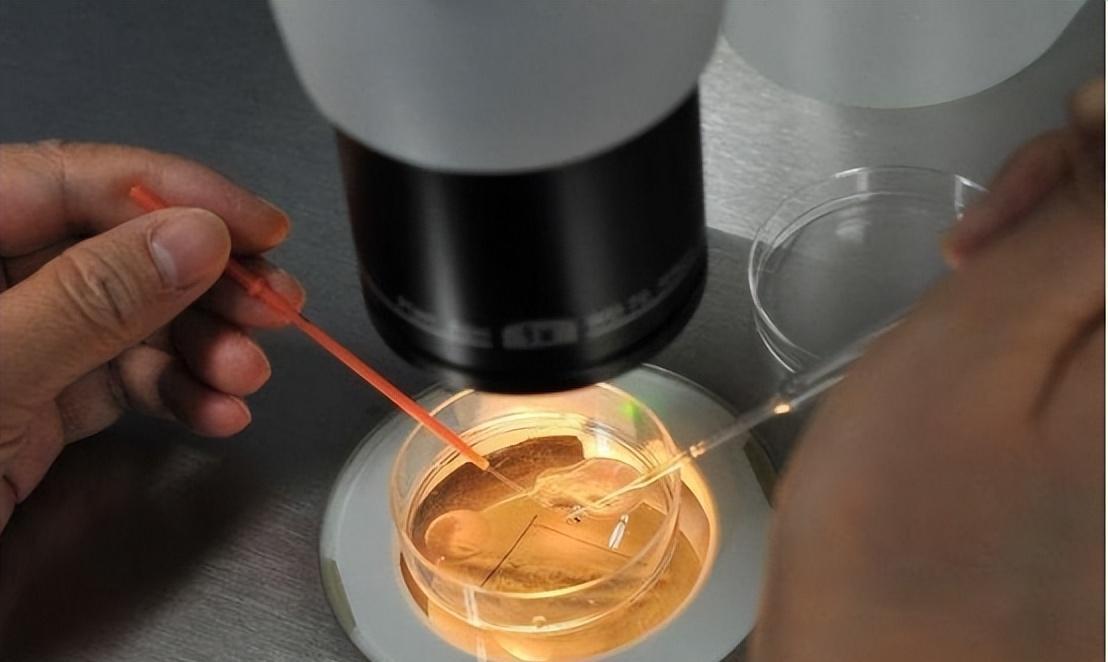
“五万一次，刺穿*体下**”？比*交性**易更可怕的是无*交性**易

本文内容来自于网络,若与实际情况不相符或存在侵权行为,请联系删除。本文仅在*今条头日**首发,请勿搬运。
导语:
生活中,我们常常会在校园角落或公共场所的卫生间里看到小小的广告,上面写着“招募卵子捐赠者,为了爱心与金钱”等字样。它们承诺只需短短几天,就能换来丰厚的报酬。对此,有人一笑置之,有人却被其诱惑而入,踏上了一段不同寻常的旅程。
一、暗流涌动的非法交易
与*交性**易一样,非法卵子捐赠和精子捐赠,甚至代孕,都是满足某些人对子嗣渴望的非法行为。经过多年的发展,买卖双方、中介机构、医疗机构和捐赠者之间已构建起一条完整的*市黑**产业链。

中介机构通过线上和线下渠道秘密发布广告,吸引着渴望快速致富的年轻女性。这些中介会详细记录她们的身高、年龄、学历、籍贯等个人信息,然后将这些信息提供给潜在的买家。
买家会仔细筛选这些信息,选择符合他们要求的女性。然后,中介机构会协调双方进行线下会面,在会谈结束后,签署卵子捐赠协议。

此后,捐卵者需要每天注射促排卵针。这是因为正常情况下,女性每月只会排出1-2颗成熟卵子,而为提高受孕成功率,需要更多成熟的卵子。约经过10天左右,卵泡会成熟。
此时,捐卵者将接受取卵手术,全名“经阴道卵巢穿刺取卵手术”。在全身麻醉或局部麻醉下,穿刺针会从阴道进入卵巢,然后多次穿刺成熟的卵泡,以获取卵子。

二、非法机构的取卵行为带来的伤害
有些中介公司声称这一过程不会对身体造成伤害,称这些卵子本来每个月都会被排出,这不过是金钱的诱惑。然而,事实并非如此。首先,使用促排卵针可能对女性身体造成损害。它可能引发月经不调,严重情况下可能导致卵巢早衰或诱发卵巢过度刺激综合征等问题,对生命安全构成威胁。

其次,非法取卵手术通常在私人场所或无资质的机构中进行,医疗设备简陋。即使执行这种手术的医生也未必具备执业资格。因此,取卵行为可能会对女性的子宫等器官造成损伤,甚至导致其他器官功能紊乱甚至停止运作。
最后,大部分非法捐卵所获收益都被中介抽走,捐卵者所得的微薄报酬仍需用于治疗与康复。

我国发布的《通知》明确规定:“供精、供卵只能以捐赠助人为目的,禁止买卖行为”,并对合法赠卵的适应证和基本条件提出明确要求。因此,不应轻信非法卵子捐赠的合法性主张。
三、捐卵行为引发的思考
据报道,参与地下卵子买卖的供卵者大多是年轻的底层白领或大学生。许多人不理解,明知这种行为危险且非法,为何这些女性还会选择走上这条路。这引发了深刻的思考,我们需要更深入地理解背后的原因。
随着经济的快速发展,生活费用迅速上涨。女性外出求学或工作,尤其是在大城市,生活费用高涨,但工资增长缓慢。她们的财政压力不断增加,需要寻找额外的金钱来源。
此外,有一些女大学生因为物质追求和攀比心态,日常支出迅速增加,因而借贷校园*款贷**。由于无法偿还债务,再加上性健康知识的匮乏,她们对于卵子捐赠了解甚少,最终踏上非法卵子捐赠之路。

最后,社会贫富差距的扩大,以及一些女性所遭受的不平等待遇,都使女性获得社会资源的机会远少于男性,上升通道有限。一些女性可能感到现状难以改变,因此通过非常规途径来赚取金钱。
总结:
近年来,政府对非法卵子捐赠等*市黑**行业加大了打击力度,但地下交易仍然猖獗。我们都明
了,捐卵行为带来的危害不言而喻,但要彻底扼制这一现象,需要多方共同努力。

首先,女性需要自我保护和自我教育,明辨非法卵子捐赠的风险,避免卷入其中。教育和信息传递对于减少这一问题的发生至关重要。在校园和社会中,提供更多有关性健康和法律风险的教育,可以帮助女性更好地保护自己。
其次,社会应该提供更多支持体系,帮助处于贫困和困境中的女性。减少社会贫富差距,改善女性的社会地位和资源分配,将有助于降低这些非法行为的吸引力。

最后,买家也应该深刻认识到他们的行为对女性和社会的伤害。没有需求就不会有供应,意识到买卖卵子的后果至关重要。追求合法途径获得子嗣的同时,也要尊重女性的健康和权益。
在结束这篇文章时,我们不仅需要警惕非法卵子捐赠带来的危害,也要为社会创造更多公平和平等的机会,让每个人都能够在合法和安全的环境下追求幸福。只有共同努力,才能使非法卵子捐赠这一问题渐行渐远,让社会更加健康和进步。

以上内容资料均来源于网络,本文作者无意针对,影射任何现实国家,政体,组织,种族,个人。相关数据,理论考证于网络资料,以上内容并不代表本文作者赞同文章中的律法,规则,观点,行为以及对相关资料的真实性负责。本文作者就以上或相关所产生的任何问题任何概不负责,亦不承担任何直接与间接的法律责任。